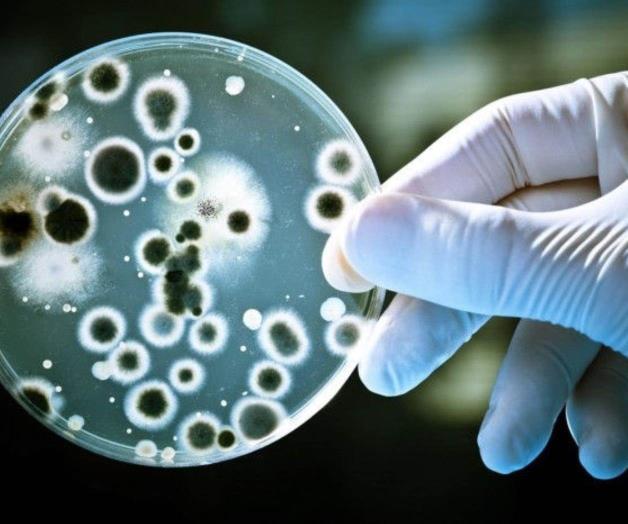
Científicos descubren bacteria que come plástico

Científicos descubren bacteria que come plástico
Las bacterias podrían ayudar a establecer un reciclado más respetuoso con el medio ambiente.
Las botellas de plástico que arrojamos a la basura hoy durarán cientos de años. Es una de las principales razones por las que el creciente problema de la contaminación provocada por los plásticos, que está teniendo una repercusión mortal sobre la vida marina, es tan grave.
Pero los científicos han descubierto recientemente una cepa de bacterias capaces literalmente de comer el plástico utilizado para fabricar botellas, y la han mejorado para hacer que trabajen con mayor rapidez. Los efectos son modestos –no es una solución completa para la contaminación causada por los plásticos– pero demuestran que las bacterias podrían ayudar a establecer un reciclado más respetuoso con el medio ambiente.
Los plásticos son polímeros complejos, lo que significa que son cadenas largas y repetitivas de moléculas que no se disuelven en agua. La resistencia de estas cadenas hace que el plástico sea muy duradero y tarde mucho tiempo en descomponerse de manera natural. Si fuese posible descomponerlos en unidades químicas más pequeñas y solubles, sería posible recoger estos componentes y reciclarlos para fabricar nuevos plásticos, como un sistema de lazo cerrado.
En 2016, unos científicos japoneses probaron diferentes bacterias de una planta de reciclado de botellas y descubrieron que la Ideonella sakaiensis 201-F6 era capaz de digerir el plástico empleado para botellas de bebidas de un solo uso, el polietileno tereftalato (PET). Funciona secretando una enzima (un tipo de proteína que acelera reacciones químicas) conocida como PETasa. Esta enzima divide varios enlaces químicos (ésteres) del PET, y deja moléculas más pequeñas que las bacterias pueden absorber, usando el carbono que hay en ellas como fuente de alimento.
Aunque ya se sabía que otras enzimas bacterianas digieren lentamente el PET, parece que la nueva enzima evolucionó específicamente para dicha tarea. Esto indica que podría ser más rápida y eficiente, por lo que sería posible utilizarla en el biorreciclaje.
En consecuencia, varios equipos están intentando descubrir cómo funciona exactamente la PETasa mediante el estudio de su estructura. En los últimos 12 meses, grupos de Corea, China y de Reino Unido, Estados Unidos y Brasil han publicado trabajos que muestran la estructura de la enzima en alta resolución y analizan sus mecanismos.
Estos artículos demuestran que la parte de la proteína PETasa que realiza la digestión química está físicamente diseñada para ligarse a las superficies del PET y funciona a 30º C, lo cual la hace apta para el reciclado en biorreactores. Dos de los equipos han demostrado también que, efectuando cambios sutiles en las propiedades químicas de la enzima para que interactúe de diferente manera con el PET, es posible hacer que funcione con más rapidez que la PETasa natural.
Utilizar enzimas de bacterias en biorreactores para descomponer el plástico y reciclarlo sigue siendo más fácil de decir que de hacer. Las propiedades físicas de los plásticos hacen que a las enzimas les resulte muy difícil interactuar con ellos.
El PET empelado en las botellas de bebidas tiene una estructura semicristalina, lo que significa que las moléculas de plástico están fuertemente comprimidas y a las enzimas les resulta difícil acceder a ellas. El estudio más reciente demuestra que la enzima mejorada probablemente funcione bien porque la parte de la molécula implicada en la reacción es muy accesible, lo cual permite a la enzima atacar incluso las moléculas de PET enterradas.
Mejoras modestasLas mejoras de la actividad de la PETasa no fueron llamativas, y todavía no estamos cerca de hallar una solución a la crisis de los plásticos. Pero esta investigación nos ayuda a entender la manera en que esta prometedora enzima descompone el PET y nos da una idea de cómo podríamos hacerla trabajar con mayor rapidez, manipulando sus partes activas.
Es relativamente inusual poder diseñar enzimas que funcionen mejor que las que han evolucionado en la naturaleza. Quizá este logro refleje el hecho de que las bacterias que usan la PETasa han evolucionado recientemente para sobrevivir a base del plástico fabricado por humanos. Esto podría dar a los científicos una interesante oportunidad de adelantar a la evolución, diseñando formas de PETasa optimizadas.
Pero hay un problema. Si bien es probable que las bacterias modificadas que se utilizan en los biorreactores estén altamente controladas, el hecho de que evolucionasen para degradar y consumir plástico indica, para empezar, que este material del que tanto dependemos podría no ser tan duradero como creíamos.
Si más bacterias no cultivadas comenzaran a comer plástico, podrían verse amenazados productos y estructuras diseñados para durar muchos años. La industria del plástico afrontaría el grave reto de impedir que estos productos se contaminaran de hambrientos microorganismos.
Las lecciones aprendidas con los antibióticos nos dicen que tardamos en tomar la delantera a las bacterias. Pero estudios como estos a lo mejor nos dan una ventaja inicial.
